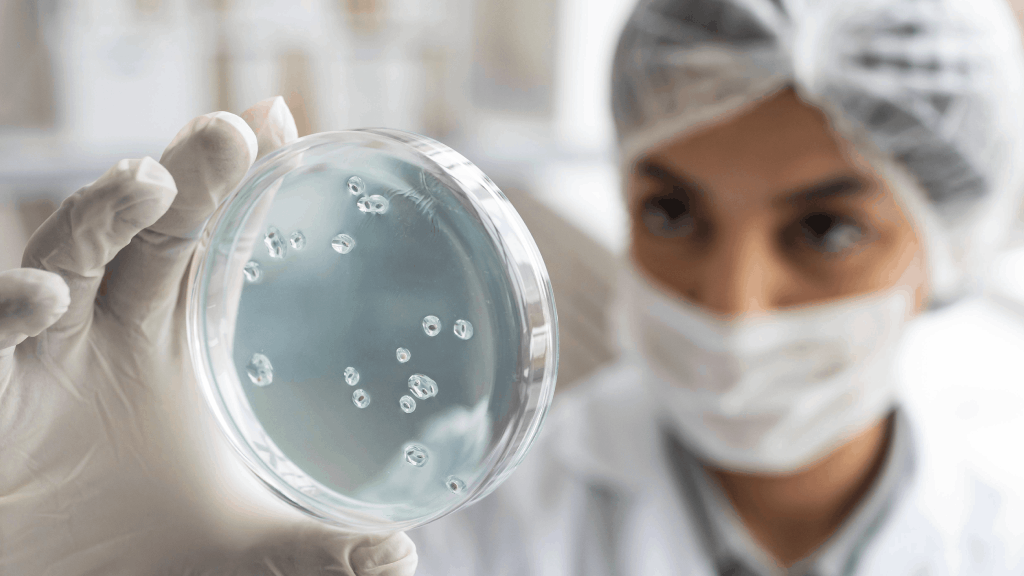

DIFFERENT TYPES OF HIGH-QUALITY
SERVICES DEPARTMENT

Prores Lab specializes in analyzing and evaluating the quality of untreated, raw water sources. Equipped with advanced technology and a team of skilled experts, they provide comprehensive testing services...
See More
We are devoted to examining and analyzing wastewater samples. We offer precise and reliable testing services to guarantee water quality compliance, discover pollutants, and promote environmental sustainabi...
See More
A leading facility, Prores Lab specializes in full testing services for the building sector. We can evaluate various building materials, including concrete, steel, wood, and insulation, thanks to our most...
See More
This lab is dedicated to the comprehensive analysis of cement and fly ash samples. Our skilled team of scientists and advanced testing equipment enable us to assess various properties, including compressiv...
See More
This leading-edge establishment provides thorough testing services for solid fuels and other minerals. Our team’s expertise and advanced equipment allow for the precise study of variables, including calori...
See More
Prores Lab is a highly regarded establishment that focuses on providing reliable and efficient microbiological testing services. The lab thoroughly tests various materials, including food, water, pharmaceu...
See More
We are a specialist institution devoted to the in-depth analysis of tea and coffee samples. Thanks to a competent team and cutting-edge machinery, we offer precise testing for factors including flavor, aro...
See More
In our testing facility for milk and dairy products, Prores Lab, we provide innovative testing services. Our highly skilled technicians and innovative equipment allow us to do in-depth tests, including det...
See More
Prores Lab is where advanced technology meets culinary exploration. Our team of passionate experts utilizes modern equipment to analyze food and agricultural samples comprehensively. From uncovering nutrit...
See More
We dive deep into the flavors and safety of your favorite meals. Our team of culinary scientists and cutting-edge tools ensure meticulous analysis of ready-to-eat food samples. From taste and texture to nu...
See More
Step into the fizz-tastic world of Prores Lab, where we unravel the mysteries hidden within your favorite bubbly beverages. Our flavor explorers and scientific sleuths analyze soft drink samples with preci...
See More